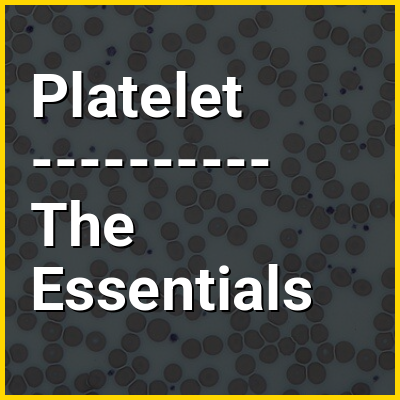

Platelets or thrombocytes (from Ancient Greek θρόμβος (thrómbos) 'clot' and κύτος (kútos) 'cell') are a part of blood whose function (along with the coagulation factors) is to react to bleeding from blood vessel injury by clumping to form a blood clot. Platelets have no cell nucleus; they are fragments of cytoplasm from megakaryocytes which reside in bone marrow or lung tissue, and then enter the circulation. Platelets are found only in mammals, whereas in other vertebrates (e.g. birds, amphibians), thrombocytes circulate as intact mononuclear cells.
One major function of platelets is to contribute to hemostasis: the process of stopping bleeding at the site where the lining of vessels (endothelium) has been interrupted. Platelets gather at the site and, unless the interruption is physically too large, they plug it. First, platelets attach to substances outside the interrupted endothelium: adhesion. Second, they change shape, turn on receptors and secrete chemical messengers: activation. Third, they connect to each other through receptor bridges: aggregation. Formation of this platelet plug (primary hemostasis) is associated with activation of the coagulation cascade, with resultant fibrin deposition and linking (secondary hemostasis). These processes may overlap: the spectrum is from a predominantly platelet plug, or "white clot" to a predominantly fibrin, or "red clot" or the more typical mixture. Berridge adds retraction and platelet inhibition as fourth and fifth steps, while others would add a sixth step, wound repair. Platelets participate in both innate and adaptive intravascular immune responses.